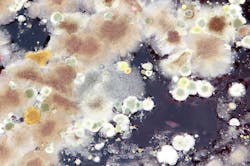
Image Image

10 Warning signs of mold plumbers can look out for
There are many indicators plumbers can proactively look out for while on the job that may point to a potential mold issue, however, they are not all used to make an absolute determination.
If you want to properly diagnose a mold issue in any property you will need to inform your customer to contact a Certified Industrial Hygienist (CIH) or an Indoor Environment Professional (IEP). The best way for a plumber to handle water damage or mold issues in a property is to simply bring it to the attention of the property owner. Here are possible indicators of a mold (the majority of plumbers have probably come across quite a few of these).
1. Standing water: If there is standing water, there is water soaking into building materials every second that the water sits. The longer it sits, the harder it will be to dry out and properly mitigate. It should be noted that water damage may lead to mold, but it doesn’t have to end up that way. Quickly addressing a water damage issue can mitigate any issues with mold growth. Remember, in order for microbial growth to occur, organic matter, moisture, warmth and oxygen must exist.
2. Water condensation: Condensation is especially problematic in older homes where there isn’t proper ventilation. In these areas, mold will commonly begin to grow on the ceiling, typically above the shower and surrounding areas. If there is a window in the area, it is recommended that it be opened during and after shower use. If there is a ventilation fan in the bathroom, it should run during and after shower use to properly ventilate the area.
3. Water staining: If you see water stains or water lines on cabinets, drywall, etc., it indicates previous water damage in the area. Why does this matter? Because this is a direct indication that there are multiple water losses in the area and it is difficult to determine how many and how severe. Water damage left untreated will often result in mold or mildew in the affected building materials.
4. Strange color: Typically, you will see a green or black substance on the building materials if mold is present, however, mold can come in all colors of the rainbow. Any discoloration in the damaged area may be an indication of microbial growth.
5. Growth on building materials: Often times people will simply be concerned by the darkening of wood after it has been wet, believing it to be mold growth. However, simple darkening of the wood doesn’t necessarily mean that there is a mold problem. Mold will usually present itself as growth on the surface of “natural” materials; wood, paper, etc., where it is provided with a food source and prime conditions for growth.
6. Musty odor: A very obvious key indicator of mold is smell. It’s usually a musty odor that smells like the basement of an old building; it is very unpleasant and should instantly be addressed.
7. Increased humidity: Even without using a hygrometer (humidity meter) you can sense increased humidity in a room. It’s like walking into a bathroom after someone has taken a shower or walking outside after a rainstorm. The air is thick and heavy; you can sense that there is a water damage issue before you even see visual indications.
8. Water damage left unmitigated: According to the Institute of Inspection, Cleaning and Restoration Certification (IICRC), microbial growth can begin as soon as 24-48 hours, depending on the conditions. For this reason, water damage restoration contractors will remove more building materials and perform a more invasive mitigation service if they believe it has been sitting for multiple days. It’s possible that mold may not be present even after several days; however, it is still not a risk that restoration contractors will want to take.
9. Confined spaces: Mold is usually going to present itself in confined areas such as crawl spaces, wall cavities, closets or behind pieces of furniture. It is in these areas that there is little to no air movement, which prevents these areas from drying out and leaves the area ideal for mold growth.
10. Health symptoms: According to the United States Environmental Protection Agency (EPA), allergic reactions to mold are common. Mold exposure can also cause asthma attacks to individuals who are allergic to mold. Allergic reactions may show up in individuals in the form of irritated eyes, skin, nose, or lungs. These are only some of the symptoms associated with mold exposure. For more information, please see a health professional.
So who should a plumber recommend to a customer if they suspect there is a mold issue? To avoid any sort of liability, plumbers should not make any diagnosis regarding mold, but should make a recommendation for a restoration contractor or CIH to inspect what may be a water damage issue. Once a restoration contractor or CIH gets involved, it most likely will not be necessary for the plumber to be involved.
Plumbers can advise customers that the American Industrial Hygiene Association (AIHA) is a good resource for finding a CIH reputable in the area. While a CIH is more than qualified for mold and water damage inspections, they can also be very costly. It may be appropriate to refer out a restoration contractor that deals with water damage and mold remediation. A restoration contractor may be able to offer a free evaluation and will be equipped to handle most routine issues. Sampling performed by a professional is required to determine whether or not there are elevated mold spores in the area.
Adam Webster co-founded Rocky Mountain Restoration in 2009 with the idea of providing an empathetic approach to restoration services. An expert in cleaning and restoration services, Webster specializes in water and fire damage restoration and has more than 10 years of experience in the property restoration industry.